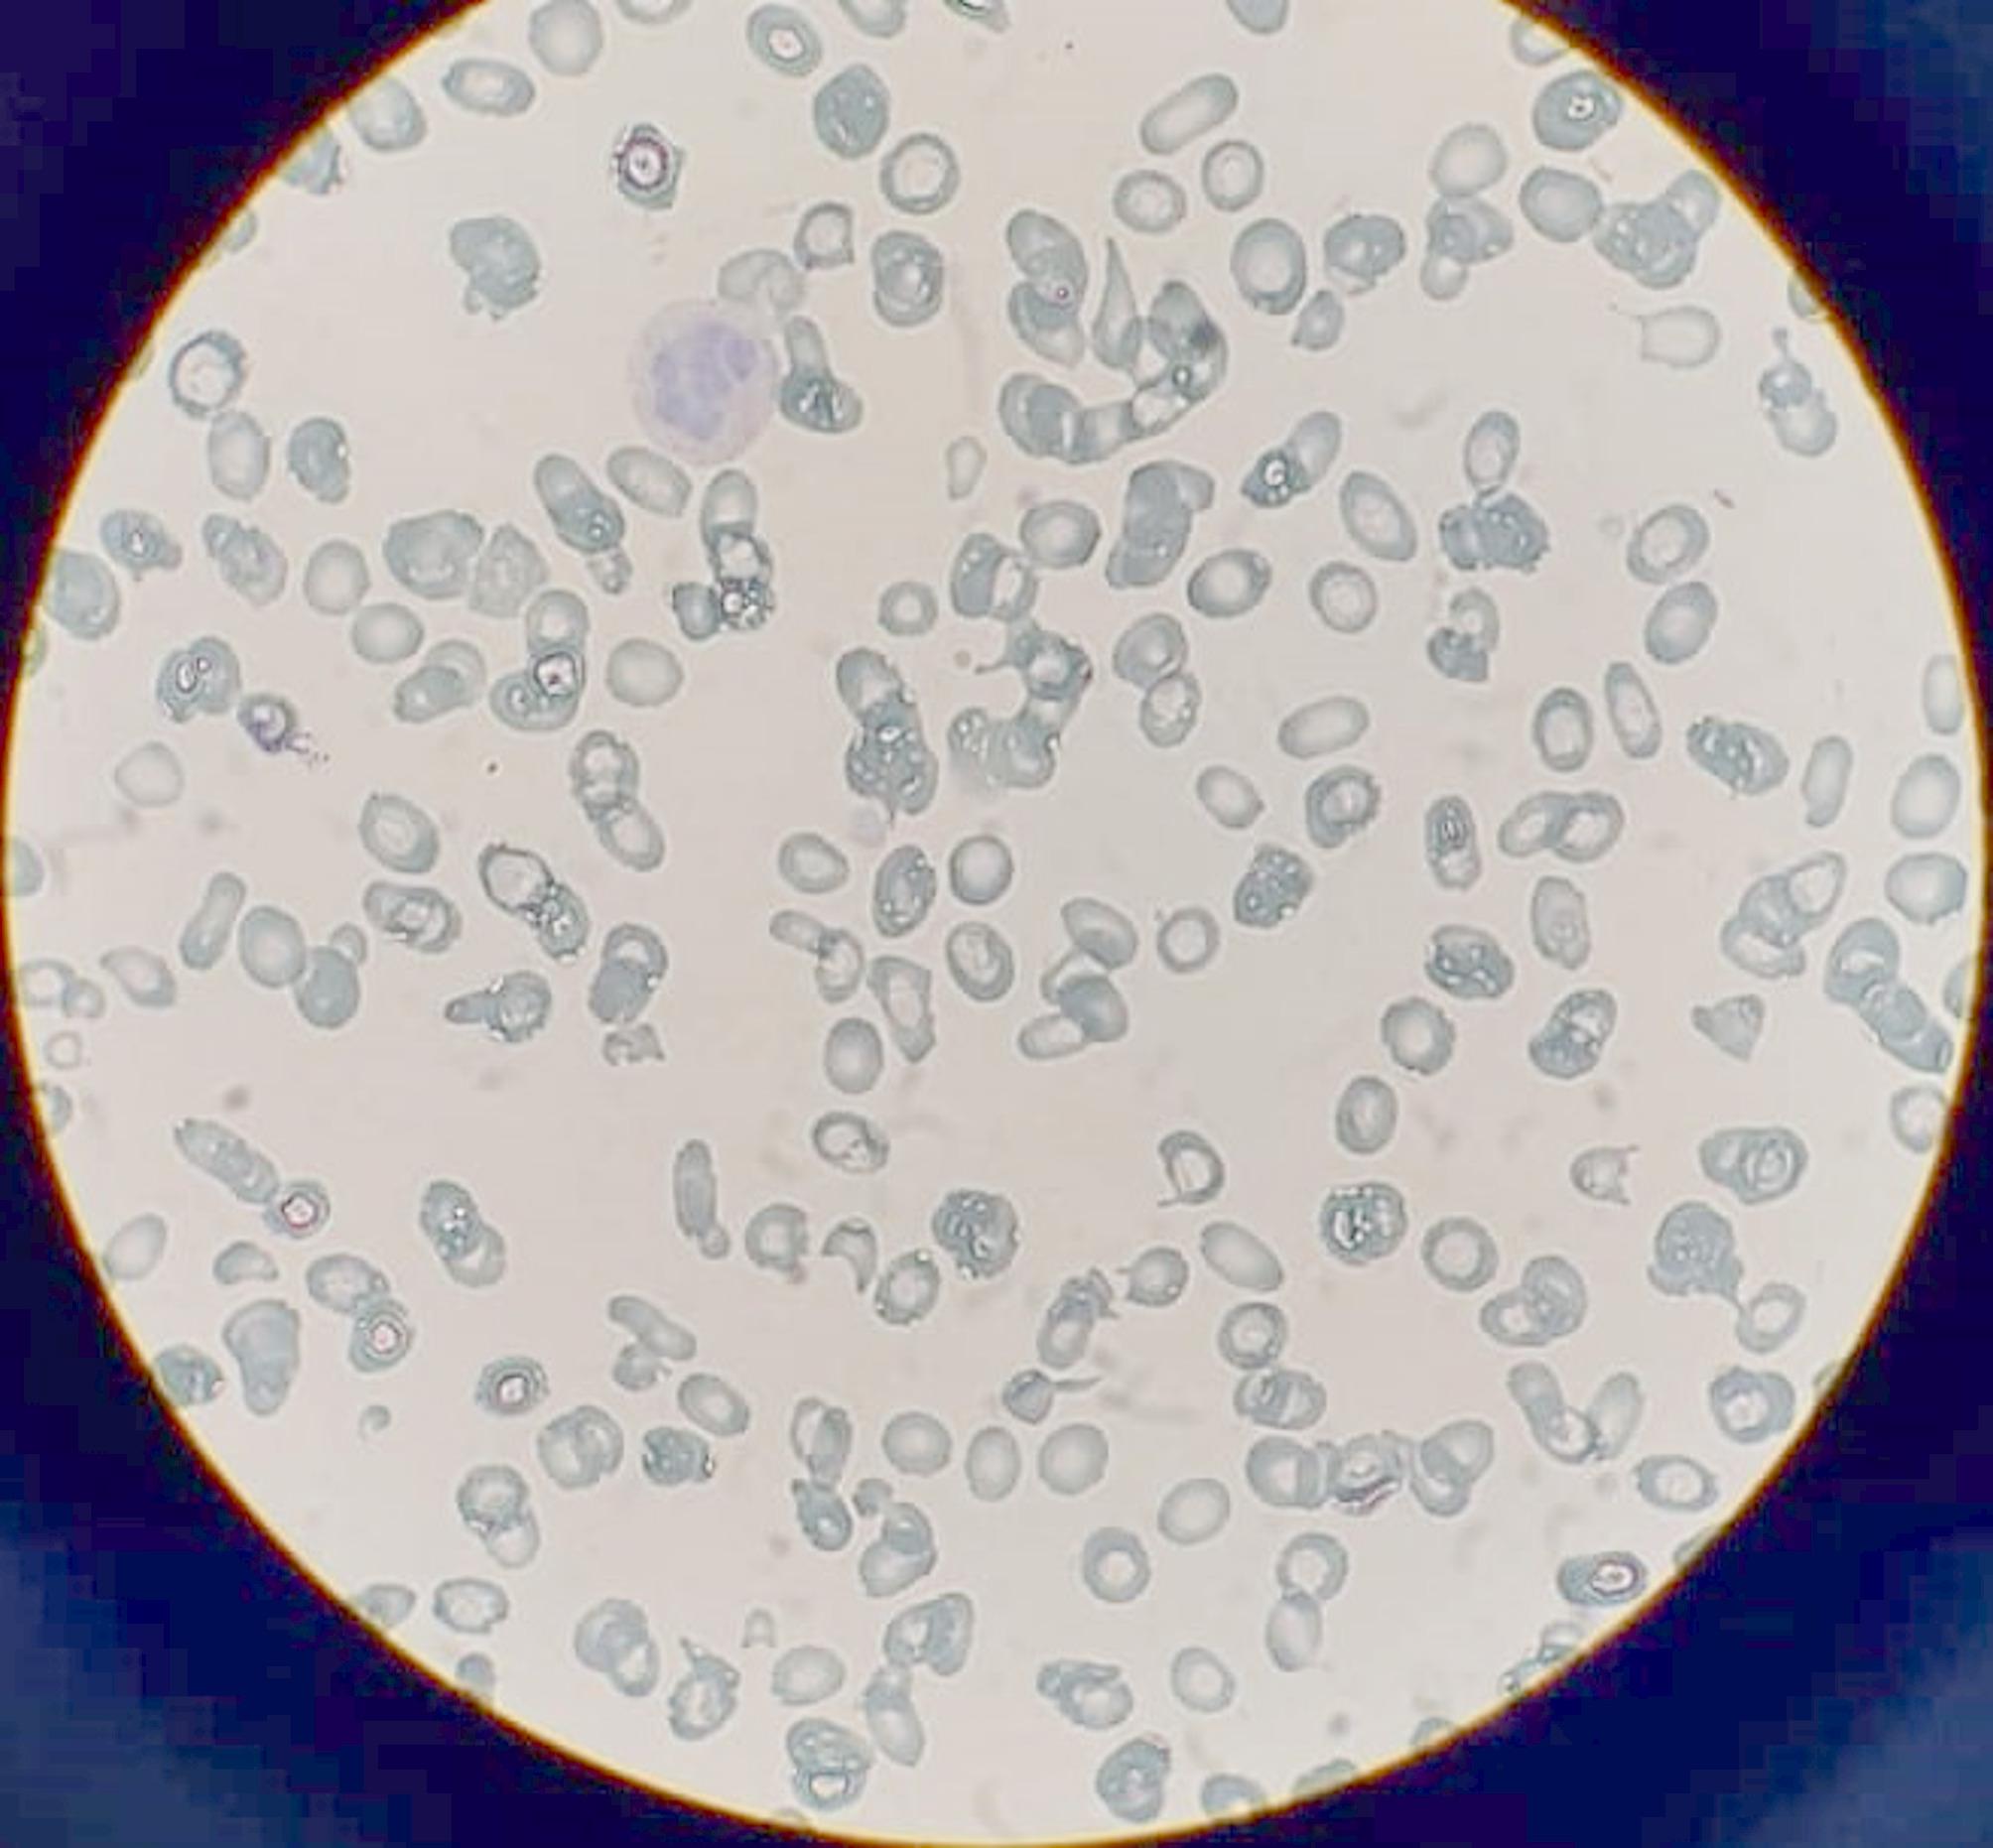

Imerslund-Gräsbeck Syndrome (IGS) is an autosomal recessive disorder caused by mutations in the CUBN or AMN genes, resulting in defective intestinal absorption of vitamin B12 and impaired protein reabsorption in renal proximal tubules [1, 2]….
Imerslund-Gräsbeck syndrome presenting with a 12-year history of intermittent proteinuria and anemia: a case from the Middle East | BMC Pediatrics